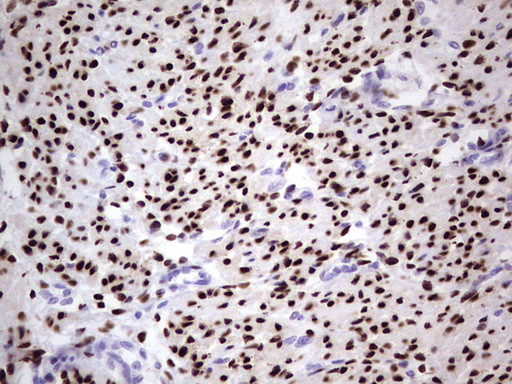
PGR Antibody in Immunohistochemistry (Paraffin) (IHC (P))

Search
OriGene
PGR Monoclonal Antibody (OTI26C2), TrueMAB™
{{$productOrderCtrl.translations['antibody.pdp.commerceCard.promotion.promotions']}}
{{$productOrderCtrl.translations['antibody.pdp.commerceCard.promotion.viewpromo']}}
{{$productOrderCtrl.translations['antibody.pdp.commerceCard.promotion.promocode']}}: {{promo.promoCode}} {{promo.promoTitle}} {{promo.promoDescription}}. {{$productOrderCtrl.translations['antibody.pdp.commerceCard.promotion.learnmore']}}
产品信息
TA805465
种属反应
宿主/亚型
分类
类型
克隆号
抗原
偶联物
形式
浓度
纯化类型
保存液
内含物
保存条件
运输条件
靶标信息
The progesterone receptor (PR) is a member of the steroid family of nuclear receptors. The PR mediates the physiological effects of progesterone, which plays a central role in reproductive events associated with the establishment and maintenance of pregnancy. PR is found as a 94 kDa protein (Form A) or a 120 kDa protein (Form B) due to the use of alternative translation initiation sites. PR-B is the transcriptionally active form and is responsible for activating genes for the maintenance of the endometrium, maintenance of pregnancy, and inhibition of ovulation. PR-A is identical to PR-B except for a 165 amino acid deletion at the N-terminus. This deletion exposes a 140 amino acid inhibitory domain (ID) that acts as a repressor of steroid hormone transcriptional activity. In its inactive state, PgR forms a multiprotein complex which includes heat shock proteins and immunophins. Upon binding of progesterone hormone to its receptor, there is a conformational change that allows dimerization and binding of the receptor to progesterone response elements (PRE) sequences, resulting in activated transcription. A Null mutation in the PGR gene leads to pleiotrophic reproductive abnormalities.
仅用于科研。不用于诊断过程。未经明确授权不得转售。
篇参考文献 (0)
生物信息学
蛋白别名: Nuclear receptor subfamily 3 group C member 3; PR; Progesterone receptor
基因别名: NR3C3; PGR; PR
UniProt ID: (Human) P06401
Entrez Gene ID: (Human) 5241